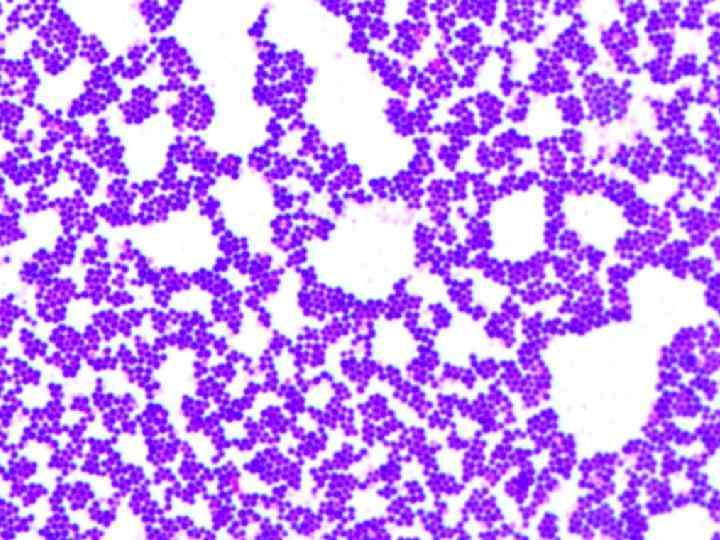
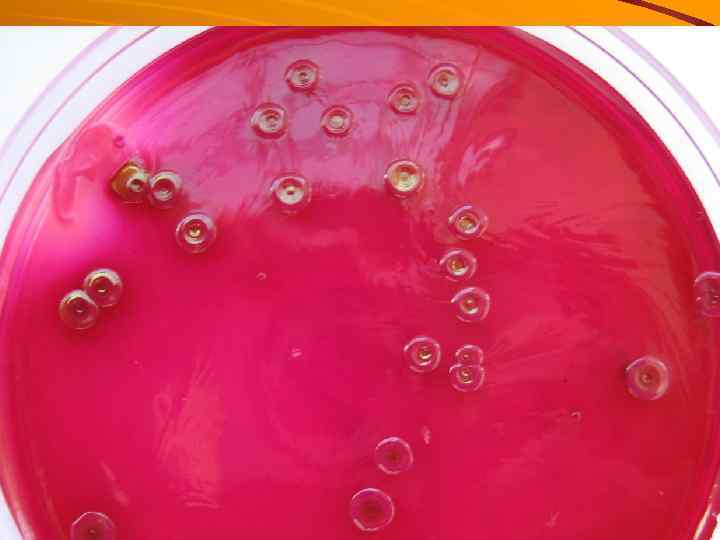

ПИЩЕВЫЕ ТОКСИКОИНФЕКЦИИ.ppt
- Количество слайдов: 51

ПИЩЕВЫЕ ТОКСИКОИНФЕКЦИИ

Пищевые токсикоинфекции (ПТИ) обширная группа зоонозных острых кишечных инфекций полиэтиологичной природы, развивающихся после употребления в пищу продуктов, инфицированных условнопатогенными бактериями, способными продуцировать экзотоксины.

Характеризуются синдромами интоксикации, гастритом, гастроэнтероколитом, часто с обезвоживанием больного

ЭТИОЛОГИЯ. Пищевые токсикоинфекции – собирательное название, объединяющее этиологически разные, но патогенетически и клинически сходные болезни. Заболевания могут вызываться различными условно-патогенными микроорганизмами свыше 30 разновидностей.

Чаще обнаруживаются возбудители ПТИ: Proteus vulgaris, Proteus mirabilis, споровыми аэробами (Bacillus cereus), споровыми анаэробами (Clostridium perfringens), Klebsiella, Enterobakter, Hafnia, Serratia, Pseudomonas, Aeromonas, Edwardsiella, В. citrobakter, гемофильными вибрионами (Vibrio parahaemalyticus), энтеротоксигенными штаммами стафилококков (St. aureus, St. albus), стрептококками (β гемолитический стрептококк группы А) и другие.

Среди бактериальных отравлений различают: - пищевые токсикоинфекции, в патогенезе которых имеют значение и бактериемия, и токсинемия; а так же пищевые интоксикации; относят ботулизм и заболевание, вызываемое энтеротоксигенными штаммами St. aureus.

ЭПИДЕМИОЛОГИЯ. Источниками ПТИ являются больные люди и животные, а также носители, которые могут инфицировать окружающую среду: почву, воду, пищу, предметы. Возможны спорадическая заболеваемость и групповые вспышки в течение всего года.

Заболевание чаще регистрируется в тёплое время года, когда имеются благоприятные условия для размножения возбудителей на пищевых продуктах.

ПАТОГЕНЕЗ Путь передачи инфекции – алиментарный. Попадая в пищевые продукты, возбудители размножаются в них, одновременно накапливаются токсические вещества (экзотоксины), что и служит причиной заболевания.

Возбудители ПТИ продуцируют токсины, как на пищевых продуктах, так и в организме человека. В ответ на массивное попадание в желудочно-кишечный тракт человека возбудителей и их токсинов в организме развиваются местные изменения – воспалительный процесс и нарушение моторики.

Цитотоксины повреждают мембраны эпителиальных клеток, что нарушает белковосинтетические процессы, развивается интоксикация.

Происходят серьёзные изменения в системах внутриклеточной регуляции метаболизма энтероцитов: циклического – 3, 5 аденозинмонофосфата (ц. АМФ) и циклического – 3, 5 гуанозинмонофосфата (ц. ГМФ), нарушение синтеза медиаторов воспаления.

Это характеризуется поражением желудочно-кишечного тракта (повышение секреции жидкости и электролитов в просвет желудка и кишечника с развитием рвоты и диареи - дегидратация), сердечно -сосудистой, нервной и других систем.

КЛИНИКА. Инкубационный период при ПТИ колеблется от 30 минут до 1 суток. При ПТИ могут поражаться: 1) желудок (гастрит); 2) тонкий кишечник (энтерит); 3) толстый кишечник (колит). Отмечаются их сочетание (гастроэнтерит, гастроэнтероколит).

Для заболевания характерны два клинических синдрома: синдром интоксикации и синдром обезвоживания.

В ряде случаев преобладает интоксикация, в других – обезвоживание, что связано с этиологией заболевания, величиной инфицирующей дозы, преморбидным состоянием больного, в том числе, состоянием его желудочно-кишечного тракта и иммунной системы.

Основными проявлениями ПТИ являются: тошнота с последующей рвотой – до 5 раз в сутки при лёгком течении болезни, от 5 до 10 - 15 раз в сутки при средней тяжести течения, свыше 15 раз в сутки – при тяжёлом течении;

жидкий стул – до 10 раз в сутки при лёгком течении болезни, от 10 до 20 раз в сутки при среднетяжёлом течении, свыше 20 раз в сутки при тяжёлом течении.

Температура при лёгком течении ПТИ может быть нормальной или субфебрильной, при среднетяжёлом течении повышается до 38ºС , при тяжёлом течении – может достигать 39ºС, иногда снижаться ниже 36ºС

В клинической картине ПТИ отмечаются также слабость, озноб, сухость слизистых оболочек полости рта, цианоз и акроцианоз, мышечно-суставные боли, тахипноэ, приглушение тонов сердца, тахикардия, артериальная гипотония, головная боль.

Боли в животе схваткообразного характера, в ряде случаев они носят постоянный характер, головокружение, вялость, обморочные состояния, судороги мышц конечностей, нарастающие по мере утяжеления течения болезни и состояния больного.

Необходимо отметить, что при ПТИ проявления обезвоживания в основном отмечаются в пределах первых трёх степеней.

Клинико-патогенетическая характеристика обезвоживания при холере (по В. И. Покровскому и В. В. Малееву) Степень обезвоживания Потери массы тела I Компенсированная 1 -3% Клини. Лабораточеская рные характе- данные ристика Жидкий, Уд. вес водянистый плазмы: стул 2 -5 1023 раз, рвота 1025 1 -3 раза, слабость, Нt 40 жажда, 45% сухость во Рh 7, 36 рту 7, 40

II 4 -6% Стул до 10 -15 раз в виде Компе «рисового отвара» , н обильная многократная рвота, выраженная сирова слабость, -нная. головокружение, сухость кожных покровов и слизистых, сухость во рту, жажда, снижение тургора кожи, осиплость голоса, акроцианоз, изредка судороги икроножных мышц, стоп, кистей, тахикардия, умеренная гипотония. Уд. вес плазмы: 1023 -1025 Нt 45 -55% Рh 7, 33 -7, 36 У части Больных Гипокалиемия и Гипохлоремия

III 7 лабил 9% ь-ная компе нсация Многократный, обильный стул типа «рисового отвара» , многократная, обильная рвота, значительная слабость, головокружение, сухость слизистых и кожи, снижение тургора кожи, заостренные черты лица, неутолимая жажда, сухой язык, цианоз лица, акроцианоз, продолжительные болезненные судороги мышц верхних и нижних конечностей, осиплость голоса, гипотония, Уд. вес плазмы: 1030 -1035 Нt. 55 -65% Рh 7, 30 Гипокалием ия, гипохлорем ия, азотемия, лейкоцитоз палочкояде р-ный сдвиг влево

IY деком -пенсированна я 10 Стул и рвота в начале % и болезни обильные, бол многократные, а к моменту поступления ее могут прекратиться. Резкая слабость, нередко прострация. Глаза запавшие, «темные очки» вокруг глаз, заостренные черты лица, «руки прачки» , резкое снижение тургора кожи, распространенные тонические судороги мышц конечностей и туловища, гипотермия, Уд. вес плазмы: 1038 -1050 Нt 65 -70%; Рh 7, 2; BE (10 -18) Декомпенсиров анный метаболический ацидоз. Гипокалиемия, гипохлоремия, азотемия, вязкость крови 20 ед. ; ОЦК 20 млкг. Лейкоцитоз, эритроцитоз, нейтрофиллез с увеличением палочкоядерны

Для оценки водно-электролитного баланса и степени гемоконцентрации исследуют: индекс гематокрита, относительную массу плазмы, вязкость крови, осмолярность плазмы. Гиповолемия способствует снижению центрального венозного давления (ЦВД), минутного объёма сердца и артериального давления.

Прогрессивно нарастают клинические признаки обезвоживания: снижение тургора кожи и мышц, сухость слизистых оболочек, тахикардия (реже брадикардия), адинамия, апатия, редко – нарушение сознания.

В тяжёлых случаях развивается инфекционно-токсический шок (ИТШ), гиповолемический шок. При тяжёлом течении ПТИ в большинстве случаев на ЭКГ отмечается отрицательный зубец Т, снижение сегмента ST, снижение зубца Р.

ДИАГНОСТИКА. Диагноз заболевания ставится на основании данных клинической картины, эпидемиологического анамнеза и лабораторных исследований. Для этой группы заболеваний характерны острое начало и бурное развитие, короткий инкубационный период, быстрый регресс.

Дифференциальный диагноз проводится с группой острых кишечных инфекций, необходимо помнить о сальмонеллёзах, шигеллёзах, холере, эшерихиозах, паратифах, иерсиниозе, кампилобактериозе, ботулизме, НАГ-инфекции, ротовирусном гастроэнтерите и других вирусных кишечных инфекциях.

ЛЕЧЕНИЕ. Госпитализация больных не является строго обязательной. Больные с лёгким течением болезни могут лечиться на дому. Этих больных может лечить на дому врач кабинета инфекционных заболеваний (и участковый врач) при условии ведения активного врачебного наблюдения.

Следует иметь в виду, что поначалу лёгкое течение болезни может прогрессировать.

Стационарное лечение показано больным со среднетяжёлым и тяжёлым течением болезни, детям раннего возраста, пожилым людям, с тяжёлыми сопутствующими заболеваниями (клинические показания).

По эпидемиологическим показаниям обязательно госпитализируются лица декретированных групп и из закрытых коллективов (работники пищевых предприятий; военнослужащие; проживающие в гостиницах, общежитиях и т. п. ).

Этиотропная терапия при ПТИ, как правило, не проводится. Основным методом лечения больных при ПТИ является патогенетическая дезинтоксикационная терапия.

Для восстановленяе водноэлектролитного баланса и гемодинамики показана регидратационная терапия кристаллоидными препаратами. Диета должна быть механически и химически щадящей в соответствии со столом № 4 лечебного питания.

Лечение больных ПТИ начинается с обязательной процедуры промывания желудка до чистой воды до 8 -ми часов. Затем начинают проводить регидратационную терапию в зависимости от степени обезвоживания перорально или парентерально

С целью быстрейшего восстановления функциональной деятельности желудочнокишечного тракта применяют ферментные препараты (панзинорм, панкурмин, фестал, дигестал и др. ).

Новым препаратом для лечения диареи, оказывающим патогенетическое воздействие на процессы всасывания и секреции в кишечнике, является сандостатин (соматостан).

Этот гормон увеличивает скорость всасывания воды и электролитов в тонком кишечнике, снижает концентрацию вазоактивных пептидов в крови, уменьшает частоту актов дефекации и массу кала.

При пищевых токсикоинфекциях неустановленной этиологии лица декретированных групп выписываются из стационара через 3 дня после клинического выздоровления и однократного, отрицательного посева кала, взятого через 2 дня после проводимого лечения.

Прочие контингенты выписываются не ранее, чем через 3 дня после клинического выздоровления, нормализации температуры и стула, с однократным, отрицательным посевом кала. Все реконвалесценты допускаются к работе сразу после выписки из стационара. Рекомендуется диетическое питание на 3 недели.

ПОСЛЕДУЮЩЕЕ НАБЛЮДЕНИЕ. Диспансерное наблюдение при необходимости (наличие заболеваний желудочнокишечного тракта и т. д. ) проводится у терапевта.

ПРОФИЛАКТИКА. Необходимо соблюдать санитарно- гигиенические правила на пищевых предприятиях. Медицинский контроль персонала, должен сочетаться со строгим ветеринарным контролем, надзором за здоровьем домашнего скота.

Необходимо проводить постоянную санитарнопросветительную работу среди населения и гигиеническое обучение.
ПИЩЕВЫЕ ТОКСИКОИНФЕКЦИИ.ppt